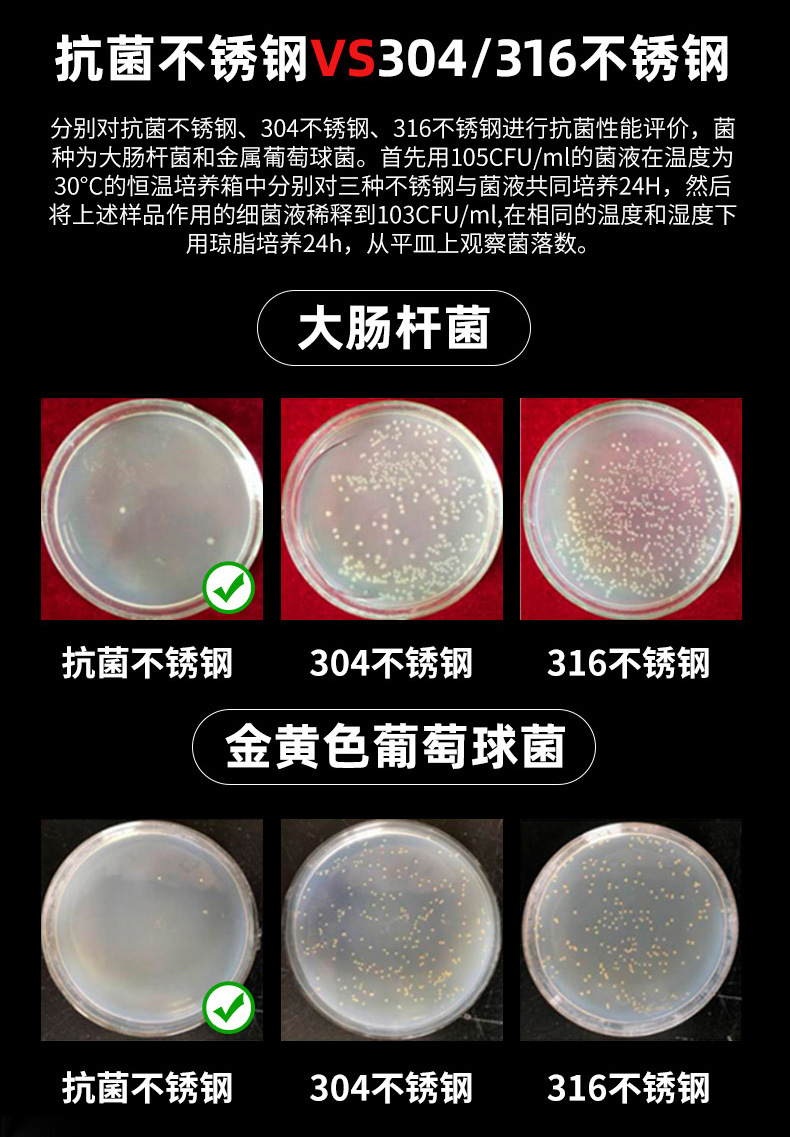
undefined

Search history
Clear allSearch by image
XDrag and drop an image here or upload an image
Max 5MB per image
UploadSign In | Join

Search history
Clear allSearch by image
XDrag and drop an image here or upload an image
Max 5MB per image
UploadSign In | Join
X Email Mobile
| medium cut-proof cutting board (rock black) + sharpener | ¥60.0 | 9802 piece available |
|
| medium double-sided plastic cutting board (tulip/text) + sharpener: collect products first shipped | ¥42.0 | 10000 piece available |
|
| medium cutting board (marble): collect products first shipped | ¥52.0 | 0 piece available |
Out of Stock
|
| affordable 304 non-slip cutting board (cartoon bear): collect products first shipped | ¥41.0 | 9948 piece available |
|
| medium cut-proof cutting board (rock black): collect products first shipped | ¥54.0 | 9307 piece available |
|
| medium cutting board (rock black) + sharpener: collect products first shipped | ¥60.0 | 0 piece available |
Out of Stock
|
| medium cutting board (rock black): collect products first shipped | ¥51.0 | 0 piece available |
Out of Stock
|
| affordable 304 non-slip cutting board (streamer years): collect products first shipped | ¥42.0 | 9970 piece available |
|
| medium cut-proof cutting board (marble) + sharpener: collect products first shipped | ¥60.0 | 9625 piece available |
|
| medium cutting board (marble) + sharpener: collect products first shipped | ¥58.0 | 0 piece available |
Out of Stock
|
| medium cut-proof cutting board (marble): collect products first shipped | ¥55.0 | 8503 piece available |
|
| medium double-sided plastic cutting board (tulip/text): collect products first shipped | ¥35.0 | 10000 piece available |
|
A new item has been added to your Shopping Cart. You now have items in your Shopping Cart.
|
|
Product Photograph 产品实拍

Update time:
TOP